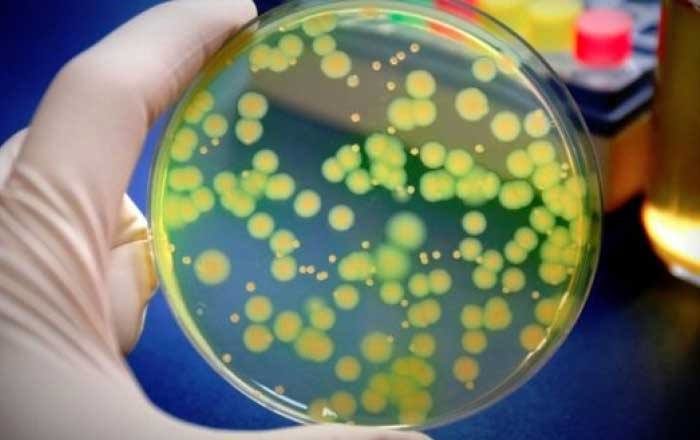
Stafilococ auriu

Stafilococ auriu: temuta bacterie din spital
Una dintre cele mai cunoscute bacterii, stafilococul auriu, este purtată de mulți dintre noi, fără să știm.
Stafilococ auriu transmitere
Pătrunderea acesteia în corp și declanșarea infecției stafilococice sunt favorizate de anumite condiții pe care trebuie să le știi.
Dacă infecția apare pe piele, provoacă, de obicei, doar inflamații relativ inofensive.
Dacă se produce însă în organism, poate să ducă la o multitudine de boli grave – afecțiuni musculare, pneumonie, infecții ale plăgilor sau, în cel mai rău caz, septicemie.
Infecție cu stafilococ auriu
Foliculita – este infecția foliculului pilos (rădăcina firului de păr) și apare ca o pustulă galbenă, rotunjită, înconjurată de o zonă roșie.
Furunculul (furunculoza) – este infecția necrotică a zonelor profunde ale unui folicul pilos, localizat pe fese, față, gât.
Este dureros, sensibil și se pot însoți de febră și alte manifestări generale.
Carbunculul – este infecția profundă a unui grup de foliculi piloși; este foarte dureroasă, fiind însoțită de alterarea stării generale și febra, apărând frecvent la bărbații adulți și vârstnici, cu localizare pe ceafă, umeri, șolduri și coapse.
Panarițiu – infecția pliurilor laterale ale unghiilor este frecvent determinată de S. aureus.
Celulita – infecția întinsă a țesutului subcutanat poate fi produsă de S. aureus, deși mai frecvent este determinată de streptococi.
Erizipelul – o erupție cu margini ridicate, bine delimitată, este o infecție superficială a dermului și țesutului subcutanat, produsă uneori și de S. aureus, deși mai frecvent are etiologie streptococică.
Practic, orice organ poate fi afectat de inflamația produsă de această bacterie.
Iar problema majoră în tratarea unei infecții cu stafilococ auriu este faptul că, în multe cazuri, acesta se dovedește a fi rezistent la meticilină (MRSA).
Caz în care tratamentul cu majoritatea antibioticelor este ineficient.
Pândește pe haine sau pe clanțele ușilor, pe comutatoarele de lumină, pe podele sau pe marginile patului.
Chiar și pe pielea noastră se simte în largul său.
Conform unor estimări recente, în Europa o treime din oameni sunt purtători ai stafilococului auriu (Staphylococcus aureus, în latină).
Dar numai câțiva dintre ei vor suferi, la un moment dat, de o infecție stafilococică.
Aceasta se declanșează atunci când imunitatea organismului scade sau când bacteria reușește să pătrundă în organism, printr-o rană deschisă sau un cateter.
In Europa o treime din oameni sunt purtători ai stafilococului auriu (Staphylococcus aureus, în latină).
Dar numai câțiva dintre ei vor suferi, la un moment dat, de o infecție stafilococică.
Aceasta se declanșează atunci când imunitatea organismului scade sau când bacteria reușește să pătrundă în organism, printr-o rană deschisă sau un cateter.
Simptomele tipice ale unei infecții cu stafilocoul auriu sunt: apariția unor umflături (edeme), iritații sau semne pe piele roșietice, senzație de greață și vomă.
Atunci când stafilococul pătrunde printr-o rană deschisă în straturile profunde ale pielii, unde se multiplică, duce la apariția unor abcese purulente, numite furuncule.
Dacă ajunge în mucoase, se va manifesta sub forma de sinuzită sau otită.
Mai grave sunt infecțiile invazive, care pot afecta orice organ:
- cistita, infecție gastro-intestinală sau mastită (în perioada de lactație)
- osteomielită
- endocardită (mai ales după înlocuirea unei valve cardiace) sau pneumonie
- septicemie
Sunt mai expuse infecțiilor stafilococice persoanele cu boli asociate (diabet, cancer), cele cu imunitatea scăzută și nou născuții.
La fel ca alți bacili periculoși, formele MRSA ale stafilococului auriu îi afectează mai ales pe pacienții internați în spitale, cărora li se administrează doze mari sau prelungite de antibiotice.
Aceste terapii medicamentoase distrug flora intestinală benefică și favorizează proliferarea bacteriei.
Aceasta va profita de sistemul imunitar deja slăbit al bolnavului și se va înmulți cu repeziciune.
Prevenirea infecției cu stafilococ auriu include, în principal, curățenia, spălarea și dezinfectarea mâinilor.
Orice rană trebuie să fie curățată bine și bandajată, astfel încât să nu permită pătrunderea bacteriilor în organism.
Pe scurt, cuvântul-cheie este igiena.
Dacă analizele au relevat prezența unei infecții cu stafilococ auriu în organism, tratamentul va consta, în principal, în administrarea unor antibiotice puternice.
În cazul infecțiilor pielii sau ale țesuturilor moi, pot fi necesare și proceduri chirurgicale.
Din păcate, în cazul germenilor MRSA (rezistenți la antibiotice) tratamentul este o ruletă rusească, întrucât chiar și cele mai avansate antibiotice pot să nu funcționeze.
Astfel de tulpini perfide sunt, din păcate, tot mai frecvente, mai ales în spitale.
Iar găsirea unui substitut adecvat pentru antibioticele care nu îi vin de hac acestui stafilococ reprezintă, în continuare, una din marile provocări ale cercetării medicale.
Alătură-te comunității noastre de cititori cu un Like pe Facebook Doftoria
Citeşte cele mai noi Articole:
Clostridium difficile: simptome, cauze și tratament
Infecţii nosocomiale: ce infecţii poți lua din spital